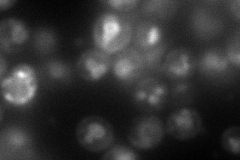
YJL012C
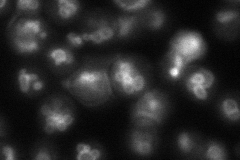
YJL012C
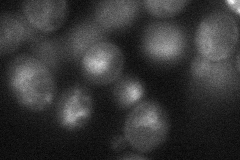
YJL012C

View description
Vacuolar membrane polyphosphate polymerase; subunit of the vacuolar transporter chaperone (VTC) complex involved in synthesis and transfer of polyP to the vacuole; regulates membrane trafficking; role in non-autophagic vacuolar fusion
Localization:
Intensity:
Fold change:
Significance:
-
C’ GFP library in SD

below threshold15.61 -
N' NOP1pr-GFP in SD

cell periphery,vacuole membrane149.904 -
N' TEF2pr-mCherry in SD
cell periphery,vacuole97.3182 -
N' NATIVEpr-GFP in SD
vacuole membrane56.5968 -
N' TEF2pr-VC and Cyto-VN in SD
ER39.2498 -
C’ GFP library in SD+DTT

cytosol14.60.93No -
C’ GFP library in SD+H2O2

cytosol14.890.95No -
C’ GFP library in Starvation Media

cytosol20.111.28No -
C’ GFP library on the background of Pup2-DaMP

below threshold -
C’ GFP library on the background of CCT mutant

below threshold16.13631.03328No
